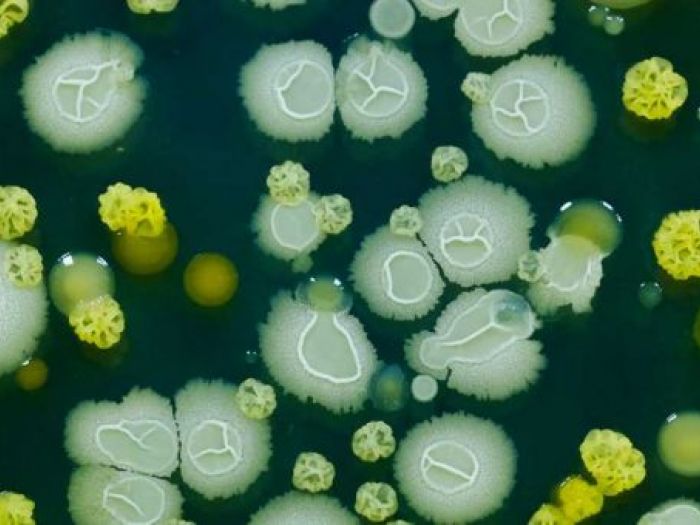
Archisio - Giesse Disinfestazioni - Progetto Disinfezioni

Giesse Disinfestazioni
Disinfezioni - Sassari (SS)
Al servizio di enti pubblici e aziende della sardegna
La giesse disinfestazioni mette a disposizione della clientela servizi relativi alle disinfezioni ambientali, che vengono effettuati sia per privati ma anche al servizio di enti pubblici e aziende. Spesso ci dimentichiamo che l’aria stessa che respiriamo è una miscela di gas e microbi.
Tutti i giorni inevitabilmente ci confrontiamo con essi. La maggioranza dei microbi ci sono del tutto indifferenti. Alcuni microbi, addirittura, ci permettono di assimilare alcuni cibi e svolgono una funzione fondamentale nella trasformazione di alcuni alimenti. Si può convivere con i microbi, basta promuovere lo sviluppo di quelli “buoni” e sfavorire ed eliminare quelli “cattivi”.
Un uso mirato di disinfettanti e antisettici deve essere la base di una sanificazione ambientale. Per quanto riguarda l’uso mirato di disinfettanti occorre valutare 2 fattori: lo spettro d’azione e il tempo d’azione. In merito all’attrezzatura specifica ci si avvale di strumenti all’avanguardia con i tempi per effettuare disinfezione ambientali impeccabili, in particolar modo nebulizzatori.
L’obiettivo di un’azione di disinfezione ambientale (in ambiente civile come un ufficio) non è ottenere un luogo sterile ma un livello igienico coerente con l’ambiente in cui si opera.
Vedi gli altri progetti
ARCHISIO
Invia una richiesta di lavoro a Giesse Disinfestazioni
Trova i migliori Disinfestazioni Derattizzazioni a
Roma| Milano| Napoli| Torino| Palermo| Genova| Bologna| Firenze| Bari| Catania| Venezia| Verona| Messina| Padova| Trieste| Taranto| Brescia| Parma| Prato| Modena| Perugia| Ravenna| Livorno| Cagliari
Vedi tutti
Trova altri professionisti a Sassari
Architetti| Imprese Edili| Imprese di Impianti Elettrici ed Elettricisti| Imprese di Traslochi| Imprese di Ponteggi| Imprese di Costruzioni Ecologiche| Ingegneri Edili| Imprese di Tende da Interni| Imprese di Bonifica Eternit| Rivenditori di Arredo Giardino ed Esterni| Rivenditori di Camini e Stufe| Rivenditori di Cucine| Geometri| Rivenditori di Illuminazione| Rivenditori di Arredamento| Rivenditori di Pavimenti e Rivestimenti| Fotografi di Interni| Rivenditori di Piscine| Designer di Interni| Artisti| Imprese di Tinteggiature| Parquettisti| Marmisti| Imprese di Impianti di Climatizzazione
Vedi tutti
Disinfestazioni Derattizzazioni vicino a te